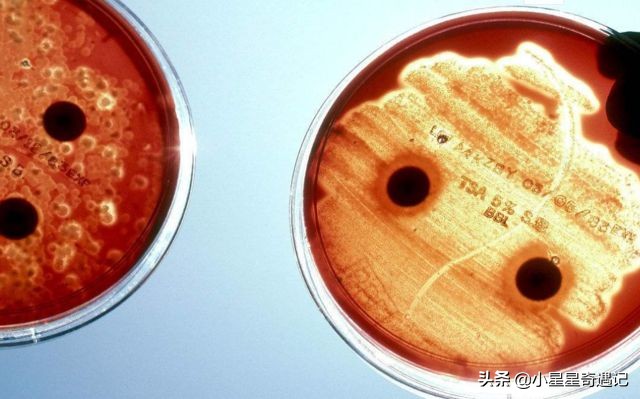
人类死亡后身体的恐怖变化,人类死之后身体会发生哪些变化

都说生老病死是人生的常态,这是我们每个人都避免不了的,一般来说,在医院的时候,如果有病人去世,我们也会遵照家属的意愿,将尸体火化,最后尘归尘,土归土,不管一个人多厉害,最后也摆脱不了死亡的命运。

这时候有好奇的人就会问。在人类死亡之后,他们的血液会去到哪里呢?下面我们就来讲一讲在人类死亡之后,身体内的血液都会流到哪里去。
血液对于我们人类的作用还是很大的。尤其是在医院的时候,医生可以通过血液检测,来判断这个人得了什么病,也可以通过血液救助别的病人。
通常来讲,我们的血型一般有分为A、B、AB、O、RH等这几种血型,当然还会有一些比较特殊的血型。

在24小时内,身体内的血液还是在运作当中的,但是身体内的热量会随着身体的律动逐渐消散。血液在受到重力的影响就会逐渐被堆积到血管内,甚至会造成血管的扩张。
在这个时候,有的红细胞就会承受不了已经发生了变化的渗透压,就会形成溶血。在24小时之后,人体内的血液就会走到人体的各个组织当中。
各个组织就会在血红蛋白的作用下被染成红色,然后它们就会被沉到身体的下部,就像是一把沙子放到水里,最后沉到水底的现象。之后人的身体就会慢慢变冷,被染成红色的血液也就会渐渐地凝结成固体,最后形成了紫色斑。
在这之后,人体别的部分就会变成白色。这也就是为什么我们在电视里面看到为什么死人的尸体都是白色的原因,这也就是为什么人死之后脸就会变得如此苍白。

一般在一些干旱的地区,就会发现有一些尸体会变得僵硬,变成了干尸,因为人身体内的水分有70%,而血液里面的水分有90%,由于在干旱地区水分蒸发得比较快,所以这些人死后也就变成了干尸了。

好了,咱们今天就先说到这里,现在你们觉得电视上面或者你在生活里面看到的一些去世的人为什么脸色十分苍白,而且有的血管扩张,还有的身体下部会有一些紫色斑了吗?以及明白人死之后的血液去了哪里了吗?